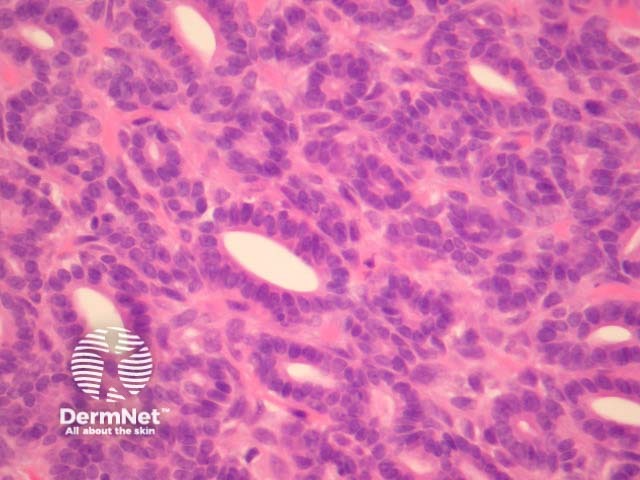
Figure 3

Main menu
Common skin conditions
NEWS
Join DermNet PRO
Read more
Quick links
Lesions (cancerous) Diagnosis and testing
Author: Assoc Prof Patrick Emanuel, Dermatopathologist, Auckland, New Zealand, 2014.
Polymorphous sweat gland carcinoma is a rare adnexal tumour and usually presents as a slow growing dermal mass on an extremity. Local recurrence is not uncommon, particularly following incomplete surgical excisions. Metastasis is rare.
Polymorphous sweat gland carcinomas are dermally based tumours (figure 1) that show a wide range of morphologic growth patterns ranging from solid, tubular (figures 2, 3), cribriform (figure 4) and ductal. Abrupt transitions between morphologies is a characteristic feature (figure 5, 6).

Figure 1

Figure 2
Figure 3

Figure 4

Figure 5

Figure 6
None are generally needed. Stains to exclude metastasis from another site can be helpful.
Adenoid cystic carcinoma – Some areas may resemble adenoid cystic carcinoma but the multiple morphologies and absence of perineural invasion favours polymorphous sweat gland carcinoma.